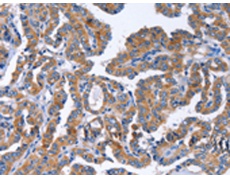
一抗

宿 主: Rabbit
相關(guān)類別: 一抗
反應(yīng)種屬: Human
標(biāo) 記 物: Unconjugate
克隆類型: rabbit polyclonal
技術(shù)規(guī)格
|
Background: |
Ig (immunoglobulin) superfamily members exhibit functional characteristics including immune responses, growth factor signaling and cell adhesion. IGSF10 (immunoglobulin superfamily, member 10), also known as Calvaria mechanical force protein 608 (CMF608), is a 2,623 amino acid secreted protein that contains an N-terminal signal peptide, six leucine-rich repeats (LRRs), and 12 immunoglobulin-like repeats. IGSF10 exists as multiple alternatively spliced isoforms, and is expressed in bone. Specifically, expression of IGSF10 is limited to mesenchymal osteochondroprogenitors with fibroblast-like morphology, where it is thought to be involved in the maintenance of the osteochondroprogenitor cells pool and its down-regulation precedes terminal differentiation. |
|
Applications: |
ELISA, IHC |
|
Name of antibody: |
IGSF10 |
|
Immunogen: |
Fusion protein of human IGSF10 |
|
Full name: |
immunoglobulin superfamily, member 10 |
|
Synonyms: |
CMF608 |
|
SwissProt: |
Q6WRI0 |
|
ELISA Recommended dilution: |
1000-5000 |
|
IHC positive control: |
Human thyroid cancer and human liver cancer |
|
IHC Recommend dilution: |
50-200 |


 購物車
購物車 幫助
幫助
 021-54845833/15800441009
021-54845833/15800441009